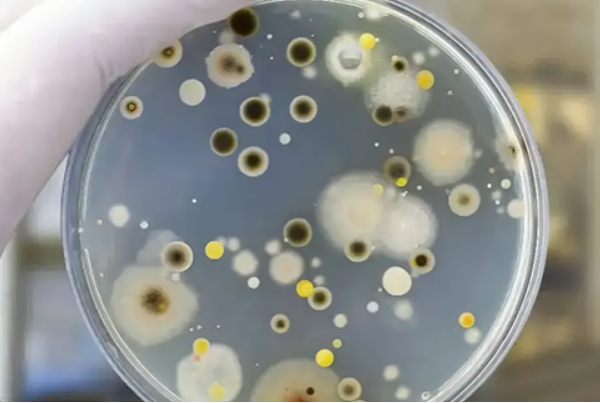
霉菌測(cè)試.png

在工業(yè)自動(dòng)化和控制系統(tǒng)中,工控機(jī)的穩(wěn)定性和可靠性至關(guān)重要。霉菌測試是評(píng)估工控機(jī)在惡劣環(huán)境下抗霉菌侵蝕能力的重要手段。本文將介紹工控機(jī)的霉菌測試過程,并探討哪些行業(yè)需要進(jìn)行霉菌測試。

一、工控機(jī)的霉菌測試
1.測試目的
重要性:霉菌測試的目的是為了評(píng)估工控機(jī)在高濕度和霉菌環(huán)境下的抵抗能力。
期望結(jié)果:通過測試,確保工控機(jī)能夠在霉菌環(huán)境中正常工作,不受到霉菌侵蝕的影響。
2.測試方法
測試環(huán)境:創(chuàng)建一個(gè)高濕度和霉菌生長的環(huán)境,模擬實(shí)際工業(yè)應(yīng)用中的惡劣條件。
測試過程:將工控機(jī)放置在測試環(huán)境中,經(jīng)過一定時(shí)間后,檢查其外觀和內(nèi)部是否有霉菌生長,以及是否影響設(shè)備的正常運(yùn)行。
3.測試標(biāo)準(zhǔn)
國際標(biāo)準(zhǔn):通常采用國際標(biāo)準(zhǔn)如IEC 60068-2-10進(jìn)行霉菌測試,以確保測試結(jié)果的準(zhǔn)確性和可靠性。
行業(yè)標(biāo)準(zhǔn):不同行業(yè)可能還有特定的霉菌測試標(biāo)準(zhǔn),需要根據(jù)具體應(yīng)用進(jìn)行選擇和遵循。
二、需要霉菌測試的行業(yè)
1.食品加工行業(yè)
原因:食品加工行業(yè)中的高濕度環(huán)境和有機(jī)物質(zhì)容易導(dǎo)致霉菌生長,對(duì)設(shè)備造成損害。
應(yīng)用:在食品加工設(shè)備中,工控機(jī)用于控制生產(chǎn)過程和監(jiān)測設(shè)備狀態(tài),因此需要進(jìn)行霉菌測試。

2.醫(yī)藥制造行業(yè)
原因:醫(yī)藥制造對(duì)環(huán)境的潔凈度要求極高,霉菌的存在可能對(duì)藥品質(zhì)量造成影響。
應(yīng)用:工控機(jī)在醫(yī)藥制造過程中負(fù)責(zé)監(jiān)控和管理生產(chǎn)線,確保產(chǎn)品的質(zhì)量和安全。
3.化工行業(yè)
原因:化工環(huán)境中的化學(xué)物質(zhì)和高濕度條件為霉菌的生長提供了有利條件。
應(yīng)用:工控機(jī)在化工生產(chǎn)過程中扮演著重要的角色,需要進(jìn)行霉菌測試以保證其穩(wěn)定性和可靠性。

三、結(jié)論
工控機(jī)的霉菌測試是確保其在惡劣環(huán)境下穩(wěn)定運(yùn)行的重要環(huán)節(jié)。通過對(duì)工控機(jī)進(jìn)行霉菌測試,可以評(píng)估其在高濕度和霉菌環(huán)境中的抵抗能力,從而保證其在食品加工、醫(yī)藥制造和化工等行業(yè)中的應(yīng)用安全和可靠性。在選擇工控機(jī)時(shí),應(yīng)考慮其是否通過了霉菌測試,并根據(jù)實(shí)際應(yīng)用環(huán)境選擇合適的產(chǎn)品。





9939
